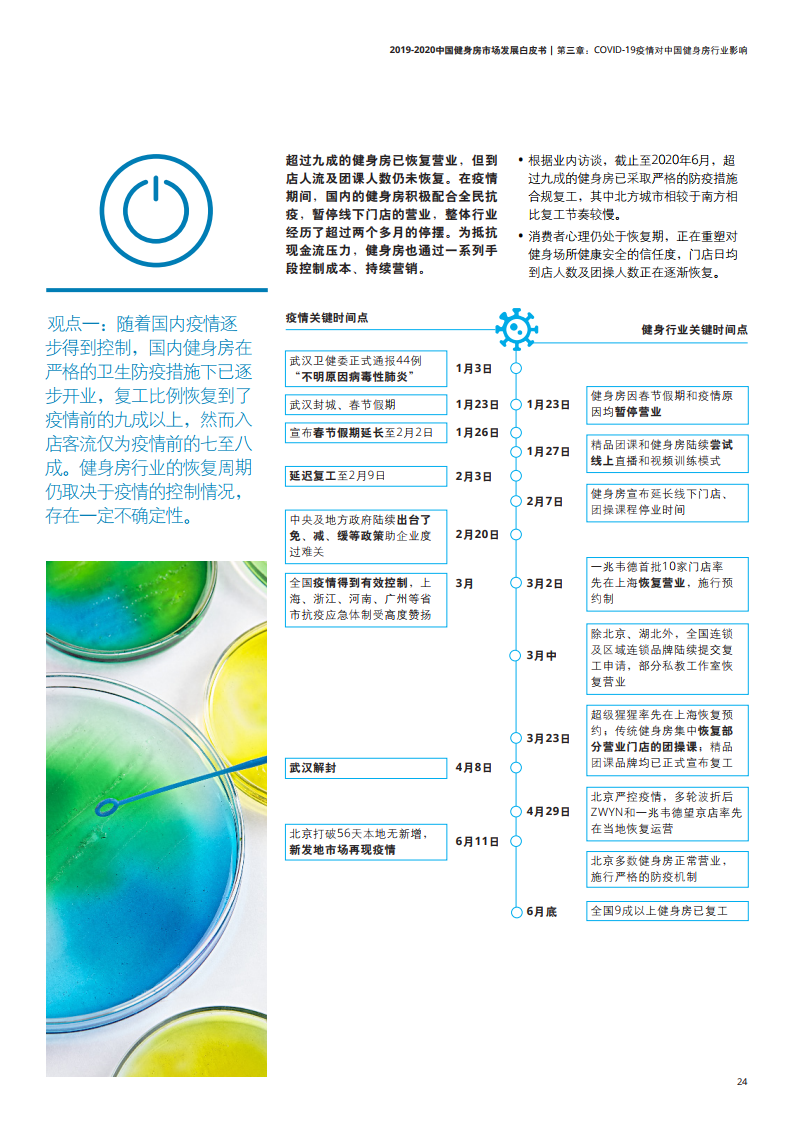

国内的健身行业正值加速发展的良好时机,国民健身房渗透率逐渐增长接近4%,领先市场约6.5%,虽然与国际市场存在一定差距,但国民健身需求开发空间大,所处的增量现阶段可以满足线下健身房的扩张。
- 市场驱动因素:中国健身行业受政策利好、消费升级和健身意识提升及“互联网+”驱动,未来市场内部产业转型升级、市场规模增长可期。
- 竞争格局:国内市场格局分散,品牌区域型特征明显,资本介入下有望产生全国性龙头品牌,细分市场逐渐丰富并呈现明显差异化,行业消费分级显现。
- 商业模式:伴随行业洗牌,健身房品牌积极优化商业模式,在会籍服务外增强私教、团课和其他增值服务,并效仿成熟市场探索多类型收费模式,行业趋向透明化、专业化、规范化,带动健身周边产业发展。
PDF版本将分享到199IT知识星球,扫描下面二维码即可!
更多阅读: